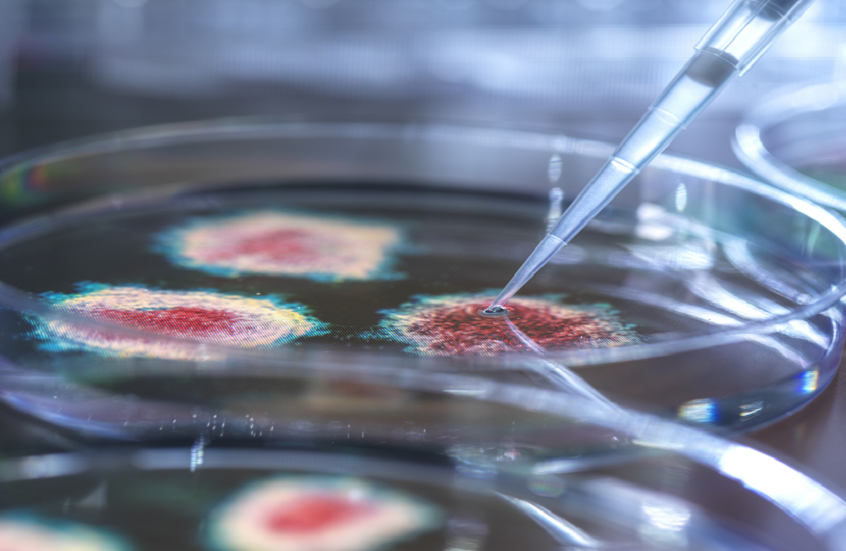
بفضل قطة.. اكتشاف فيروس "غير مسبوق" قد يشكل تهديدا للبشر

Stories
-
![مونديال 2026]()
مونديال 2026
RT STORIES
كرواتيا تنعش آمالها وتقصي بنما من كأس العالم 2026
![كرواتيا تنعش آمالها وتقصي بنما من كأس العالم 2026]() #اسأل_أكثر #Question_More
#اسأل_أكثر #Question_MoreRT STORIES
نبض اليوم الـ14 من المونديال.. حسم بطاقات العبور ومواجهات لا تقبل القسمة على اثنين
![نبض اليوم الـ14 من المونديال.. حسم بطاقات العبور ومواجهات لا تقبل القسمة على اثنين]() #اسأل_أكثر #Question_More
#اسأل_أكثر #Question_MoreRT STORIES
رد فعل رونالدو عندما تلقى سؤالا عن ميسي
![رد فعل رونالدو عندما تلقى سؤالا عن ميسي]() #اسأل_أكثر #Question_More
#اسأل_أكثر #Question_MoreRT STORIES
أول تعليق لرونالدو بعد تحطيمه رقمين قياسيين في مباراة أوزبكستان
![أول تعليق لرونالدو بعد تحطيمه رقمين قياسيين في مباراة أوزبكستان]() #اسأل_أكثر #Question_More
#اسأل_أكثر #Question_MoreRT STORIES
في ليلة تاريخية لرونالدو.. البرتغال تكتسح أوزبكستان بخماسية نظيفة
![في ليلة تاريخية لرونالدو.. البرتغال تكتسح أوزبكستان بخماسية نظيفة]() #اسأل_أكثر #Question_More
#اسأل_أكثر #Question_MoreRT STORIES
رقمان قياسيان في 45 دقيقة.. رونالدو يخلد اسمه في تاريخ كأس العالم
![رقمان قياسيان في 45 دقيقة.. رونالدو يخلد اسمه في تاريخ كأس العالم]() #اسأل_أكثر #Question_More
#اسأل_أكثر #Question_MoreRT STORIES
ماذا يتغير قبل تنفيذ ركلات الترجيح؟.. "الفيفا" يجهز تعديلا جديدا في كأس العالم
![ماذا يتغير قبل تنفيذ ركلات الترجيح؟.. "الفيفا" يجهز تعديلا جديدا في كأس العالم]() #اسأل_أكثر #Question_More
#اسأل_أكثر #Question_MoreRT STORIES
بعد تألقه في كأس العالم.. محمد صلاح يجني 3 مكاسب
![بعد تألقه في كأس العالم.. محمد صلاح يجني 3 مكاسب]() #اسأل_أكثر #Question_More
#اسأل_أكثر #Question_MoreRT STORIES
بعد الفوز على الأردن.. هذه سيناريوهات تأهل الجزائر إلى دور الـ32 في مونديال 2026
![بعد الفوز على الأردن.. هذه سيناريوهات تأهل الجزائر إلى دور الـ32 في مونديال 2026]() #اسأل_أكثر #Question_More
#اسأل_أكثر #Question_MoreRT STORIES
أول تعليق من جمال السلامي بعد خسارة الأردن أمام الجزائر
![أول تعليق من جمال السلامي بعد خسارة الأردن أمام الجزائر]() #اسأل_أكثر #Question_More
#اسأل_أكثر #Question_MoreRT STORIES
رسميا.. برشلونة يعلن تفعيل بند شراء حمزة عبد الكريم
![رسميا.. برشلونة يعلن تفعيل بند شراء حمزة عبد الكريم]() #اسأل_أكثر #Question_More
#اسأل_أكثر #Question_MoreRT STORIES
الموعد والقنوات الناقلة لمباراة البرتغال وأوزبكستان في كأس العالم
![الموعد والقنوات الناقلة لمباراة البرتغال وأوزبكستان في كأس العالم]() #اسأل_أكثر #Question_More
#اسأل_أكثر #Question_MoreRT STORIES
هل تلقى إمام عاشور عرضا من الدوري الأمريكي؟.. شوبير يحسم الأمر
![هل تلقى إمام عاشور عرضا من الدوري الأمريكي؟.. شوبير يحسم الأمر]() #اسأل_أكثر #Question_More
#اسأل_أكثر #Question_MoreRT STORIES
رد فعل ولي العهد الأردني بعد الخسارة أمام الجزائر في كأس العالم (صورة)
![رد فعل ولي العهد الأردني بعد الخسارة أمام الجزائر في كأس العالم (صورة)]() #اسأل_أكثر #Question_More
#اسأل_أكثر #Question_MoreRT STORIES
مبابي يكسر صمته بشأن رقم ميسي القياسي في كأس العالم
![مبابي يكسر صمته بشأن رقم ميسي القياسي في كأس العالم]() #اسأل_أكثر #Question_More
#اسأل_أكثر #Question_MoreRT STORIES
"النشامى" يودع كأس العالم 2026 رغم الأداء المشرف
!["النشامى" يودع كأس العالم 2026 رغم الأداء المشرف]() #اسأل_أكثر #Question_More
#اسأل_أكثر #Question_MoreRT STORIES
النرويج تكتب التاريخ وتحتفل بأسلوب "الفايكينغ" بعد إسقاط السنغال (فيديو)
![النرويج تكتب التاريخ وتحتفل بأسلوب "الفايكينغ" بعد إسقاط السنغال (فيديو)]() #اسأل_أكثر #Question_More
#اسأل_أكثر #Question_MoreRT STORIES
الجزائر تقلب الطاولة على الأردن وتفوز 2-1 في مونديال 2026
![الجزائر تقلب الطاولة على الأردن وتفوز 2-1 في مونديال 2026]() #اسأل_أكثر #Question_More
#اسأل_أكثر #Question_MoreRT STORIES
ما المنتخبات المتأهلة إلى دور الـ32 من كأس العالم 2026؟
![ما المنتخبات المتأهلة إلى دور الـ32 من كأس العالم 2026؟]() #اسأل_أكثر #Question_More
#اسأل_أكثر #Question_MoreRT STORIES
هالاند يكتب التاريخ.. أرقام قياسية جديدة في كأس العالم 2026
![هالاند يكتب التاريخ.. أرقام قياسية جديدة في كأس العالم 2026]() #اسأل_أكثر #Question_More
#اسأل_أكثر #Question_MoreRT STORIES
بعد ثنائية في شباك العراق.. مبابي يواصل التحطيم ويقترب من ميسي في صدارة تاريخية
![بعد ثنائية في شباك العراق.. مبابي يواصل التحطيم ويقترب من ميسي في صدارة تاريخية]() #اسأل_أكثر #Question_More
#اسأل_أكثر #Question_MoreRT STORIES
النرويج تحسم الإثارة أمام السنغال 3-2 في مباراة درامية
![النرويج تحسم الإثارة أمام السنغال 3-2 في مباراة درامية]() #اسأل_أكثر #Question_More
#اسأل_أكثر #Question_MoreRT STORIES
فرنسا تكتسح العراق بثلاثية وتحجز مقعدها في دور الـ32
![فرنسا تكتسح العراق بثلاثية وتحجز مقعدها في دور الـ32]() #اسأل_أكثر #Question_More
#اسأل_أكثر #Question_More![مونديال 2026]() مونديال 2026
مونديال 2026
-
![اتفاق أمريكي إيراني لوقف الحرب على جميع الجبهات]()
اتفاق أمريكي إيراني لوقف الحرب على جميع الجبهات
RT STORIES
السفير الإسرائيلي في واشنطن: نحن في وضع كارثي بسبب حزب الله
![السفير الإسرائيلي في واشنطن: نحن في وضع كارثي بسبب حزب الله]() #اسأل_أكثر #Question_More
#اسأل_أكثر #Question_MoreRT STORIES
ترامب: نغادر إيران الآن وهي دون قدرات صاروخية أو برنامج نووي
![ترامب: نغادر إيران الآن وهي دون قدرات صاروخية أو برنامج نووي]() #اسأل_أكثر #Question_More
#اسأل_أكثر #Question_MoreRT STORIES
تماشيا مع مشاورات أمريكا وإيران.. سلطنة عمان تعلن فتح ممر مؤقت في هرمز بالتنسيق "البحرية الدولية"
![تماشيا مع مشاورات أمريكا وإيران.. سلطنة عمان تعلن فتح ممر مؤقت في هرمز بالتنسيق "البحرية الدولية"]() #اسأل_أكثر #Question_More
#اسأل_أكثر #Question_MoreRT STORIES
شهباز شريف: برنامج الصواريخ الباليستية الإيراني لم يكن مطروحا في التفاهمات مع واشنطن
![شهباز شريف: برنامج الصواريخ الباليستية الإيراني لم يكن مطروحا في التفاهمات مع واشنطن]() #اسأل_أكثر #Question_More
#اسأل_أكثر #Question_MoreRT STORIES
استطلاع رأي الأمريكيين: حرب إيران لم تستحق التكلفة
![استطلاع رأي الأمريكيين: حرب إيران لم تستحق التكلفة]() #اسأل_أكثر #Question_More
#اسأل_أكثر #Question_MoreRT STORIES
بزشكيان: إيران لن تتفاوض أبدا على قدراتها الدفاعية
![بزشكيان: إيران لن تتفاوض أبدا على قدراتها الدفاعية]() #اسأل_أكثر #Question_More
#اسأل_أكثر #Question_MoreRT STORIES
ترامب: مفتشو الوكالة الدولية للطاقة الذرية سيزورون إيران في الوقت المناسب
![ترامب: مفتشو الوكالة الدولية للطاقة الذرية سيزورون إيران في الوقت المناسب]() #اسأل_أكثر #Question_More
#اسأل_أكثر #Question_MoreRT STORIES
الحرس الثوري يحسم الجدل حول عدد السفن المسموح لها بعبور مضيق هرمز
![الحرس الثوري يحسم الجدل حول عدد السفن المسموح لها بعبور مضيق هرمز]() #اسأل_أكثر #Question_More
#اسأل_أكثر #Question_MoreRT STORIES
طهران: مفاوضات سويسرا لم تبحث الملف النووي ورفع العقوبات
![طهران: مفاوضات سويسرا لم تبحث الملف النووي ورفع العقوبات]() #اسأل_أكثر #Question_More
#اسأل_أكثر #Question_MoreRT STORIES
لافروف: من الخطأ أن تتحد الدول العربية ضد إيران ولم نلمس مثل هذا التوجه
![لافروف: من الخطأ أن تتحد الدول العربية ضد إيران ولم نلمس مثل هذا التوجه]() #اسأل_أكثر #Question_More
#اسأل_أكثر #Question_MoreRT STORIES
بزشكيان: تقدم المفاوضات مرهون بالالتزام الأمريكي
![بزشكيان: تقدم المفاوضات مرهون بالالتزام الأمريكي]() #اسأل_أكثر #Question_More
#اسأل_أكثر #Question_MoreRT STORIES
طهران وواشنطن تشكلان 4 مجموعات عمل بعد مفاوضات سويسرا
![طهران وواشنطن تشكلان 4 مجموعات عمل بعد مفاوضات سويسرا]() #اسأل_أكثر #Question_More
#اسأل_أكثر #Question_MoreRT STORIES
ترامب حول رفض إسرائيل سحب القوات من لبنان: أعمل على حل المشاكل بما فيها تلك التي تتعلق بنتنياهو
![ترامب حول رفض إسرائيل سحب القوات من لبنان: أعمل على حل المشاكل بما فيها تلك التي تتعلق بنتنياهو]() #اسأل_أكثر #Question_More
#اسأل_أكثر #Question_More![اتفاق أمريكي إيراني لوقف الحرب على جميع الجبهات]() اتفاق أمريكي إيراني لوقف الحرب على جميع الجبهات
اتفاق أمريكي إيراني لوقف الحرب على جميع الجبهات
-
![العملية العسكرية الروسية في أوكرانيا]()
العملية العسكرية الروسية في أوكرانيا
RT STORIES
ريابكوف يحذر الغرب: لا تشكوا في تصميم روسيا على تحقيق أهداف العملية العسكرية
![ريابكوف يحذر الغرب: لا تشكوا في تصميم روسيا على تحقيق أهداف العملية العسكرية]() #اسأل_أكثر #Question_More
#اسأل_أكثر #Question_MoreRT STORIES
مقتل عامل بلدية وإصابة 3 نساء جراء هجوم أوكراني على إنيرغودار قرب محطة زابوروجيه النووية
![مقتل عامل بلدية وإصابة 3 نساء جراء هجوم أوكراني على إنيرغودار قرب محطة زابوروجيه النووية]() #اسأل_أكثر #Question_More
#اسأل_أكثر #Question_MoreRT STORIES
الخارجية الأوكرانية: زيلينسكي لن يتوجه إلى بولندا لتجنب فضائح
![الخارجية الأوكرانية: زيلينسكي لن يتوجه إلى بولندا لتجنب فضائح]() #اسأل_أكثر #Question_More
#اسأل_أكثر #Question_MoreRT STORIES
توسك: مؤتمر أوكرانيا سيكون أكثر جدوى بدون زيلينسكي
![توسك: مؤتمر أوكرانيا سيكون أكثر جدوى بدون زيلينسكي]() #اسأل_أكثر #Question_More
#اسأل_أكثر #Question_MoreRT STORIES
ريابكوف: الولايات المتحدة تبتعد عن تفاهمات أنكوريدج حول تسوية للأزمة الأوكرانية
![ريابكوف: الولايات المتحدة تبتعد عن تفاهمات أنكوريدج حول تسوية للأزمة الأوكرانية]() #اسأل_أكثر #Question_More
#اسأل_أكثر #Question_MoreRT STORIES
ريابكوف: مواجهة مباشرة مع الغرب ستقود إلى عواقب كارثية وروسيا ستتخذ إجراءات مضادة في بحر البلطيق
![ريابكوف: مواجهة مباشرة مع الغرب ستقود إلى عواقب كارثية وروسيا ستتخذ إجراءات مضادة في بحر البلطيق]() #اسأل_أكثر #Question_More
#اسأل_أكثر #Question_MoreRT STORIES
زاخاروفا: اليورانيوم المخصص لأوكرانيا قد يصل إلى مصنع في دولة ثالثة
![زاخاروفا: اليورانيوم المخصص لأوكرانيا قد يصل إلى مصنع في دولة ثالثة]() #اسأل_أكثر #Question_More
#اسأل_أكثر #Question_MoreRT STORIES
ضربات روسية دقيقة تدمر معقلا أوكرانيا في مقاطعة زابوروجيه
#اسأل_أكثر #Question_MoreRT STORIES
كونستانتينوفكا.. وحدات المدفعية الروسية تستهدف مواقع مسلحي القوات الأوكرانية
#اسأل_أكثر #Question_MoreRT STORIES
لافروف: لا أريد حتى مجرد الاشتباه بأن قمة "ألاسكا" صممت لكسب الوقت لتسليح كييف
![لافروف: لا أريد حتى مجرد الاشتباه بأن قمة "ألاسكا" صممت لكسب الوقت لتسليح كييف]() #اسأل_أكثر #Question_More
#اسأل_أكثر #Question_MoreRT STORIES
ارتفاع حصيلة مصابي الاعتداء الإرهابي الأوكراني على حافلة في دونيتسك إلى 17 شخصا
![ارتفاع حصيلة مصابي الاعتداء الإرهابي الأوكراني على حافلة في دونيتسك إلى 17 شخصا]() #اسأل_أكثر #Question_More
#اسأل_أكثر #Question_MoreRT STORIES
لافروف: روسيا مستعدة لاتخاذ كافة التدابير لحماية دولة الاتحاد بين روسيا وبيلاروس
![لافروف: روسيا مستعدة لاتخاذ كافة التدابير لحماية دولة الاتحاد بين روسيا وبيلاروس]() #اسأل_أكثر #Question_More
#اسأل_أكثر #Question_MoreRT STORIES
أوشاكوف: إدارة ترامب سعت لحل نزاع أوكرانيا خلافا لإدارة بايدن
![أوشاكوف: إدارة ترامب سعت لحل نزاع أوكرانيا خلافا لإدارة بايدن]() #اسأل_أكثر #Question_More
#اسأل_أكثر #Question_MoreRT STORIES
القوات الأوكرانية تنسحب من أطراف قسطنطينوفكا تحت ضغط التقدم الروسي
![القوات الأوكرانية تنسحب من أطراف قسطنطينوفكا تحت ضغط التقدم الروسي]() #اسأل_أكثر #Question_More
#اسأل_أكثر #Question_MoreRT STORIES
مقتل خمسة أشخاص في هجوم صاروخي أوكراني على فورونيج
![مقتل خمسة أشخاص في هجوم صاروخي أوكراني على فورونيج]() #اسأل_أكثر #Question_More
#اسأل_أكثر #Question_More![العملية العسكرية الروسية في أوكرانيا]() العملية العسكرية الروسية في أوكرانيا
العملية العسكرية الروسية في أوكرانيا
-
فيديوهات
RT STORIES
مسقط.. السلطان هيثم يستقبل قاليباف
#اسأل_أكثر #Question_MoreRT STORIES
الصين.. شركة "ديب روبوتيكس" الصينية تكشف عن كلب آلي لمكافحة الحرائق
#اسأل_أكثر #Question_MoreRT STORIES
الولايات المتحدة.. رياح عاتية تلحق أضرارا واسعة في ولاية إنديانا
#اسأل_أكثر #Question_MoreRT STORIES
لبنان.. فعالية بمناسبة "يوم الذكرى والحزن" في بيروت بعد مرور 85 عاما على بدء الحرب الوطنية العظمى
#اسأل_أكثر #Question_MoreRT STORIES
غزة.. الطائرات الإسرائيلية تستهدف سيارة في حي الرمال
#اسأل_أكثر #Question_Moreفيديوهات
-
![ترامب يتهكم مجددا على مشاركة المتحولين جنسيا في المنافسات النسائية (فيديو)]()
ترامب يتهكم مجددا على مشاركة المتحولين جنسيا في المنافسات النسائية (فيديو)
RT STORIES
ترامب يتهكم مجددا على مشاركة المتحولين جنسيا في المنافسات النسائية (فيديو)
![ترامب يتهكم مجددا على مشاركة المتحولين جنسيا في المنافسات النسائية (فيديو)]() #اسأل_أكثر #Question_More
#اسأل_أكثر #Question_More
بريطانيا ترصد أول حالة بالسلالة الأخطر من جدري القردة
أعلنت وكالة الأمن الصحي البريطانية، رصد أول حالة مؤكدة بالسلالة الجديدة من فيروس جدري القردة الذي يبدو أنه انتشر بسرعة أكبر، ويعد أشد خطورة من السلالة الأخرى الموجودة بالفعل.

وذكرت وكالة "بلومبرغ" أنه تم رصد حالة إصابة بسلالة "آي بي إمبوكس" لدى مريض في لندن بعد سفره مؤخرا إلى إفريقيا، التي شهدت حالات عدوى بهذه السلالة.
ويتلقى المريض العلاج في وحدة الأمراض المعدية بمستشفى "رويال فري"، وذكرت وكالة الأمن الصحي أن الخطر على الجمهور منخفض.
يشار إلى أن بريطانيا لديها إمداد من لقاحات فيروس جدري القردة، كما اشترت المزيد من الجرعات مؤخرا من شركة "بافاريان نورديك إيه/إس".
وفي 22 أكتوبر الجاري، أفادت صحيفة "بيلد" الألمانية، بتسجيل أول إصابة بسلالة متحورة جديدة لجدري القردة في البلاد.
وكانت منظمة الصحة العالمية قد أعلنت، في وقت سابق، أن جدري القردة يمثل حالة طوارئ صحية عامة تثير قلقا دوليا.
وجدري القردة هو عدوى فيروسية نادرة يمكن أن تمثل خطرا خاصة على هؤلاء الذين يعانون من ضعف في جهاز المناعة، وتشمل أعراض المرض الحمى وتورم الغدد الليمفاوية والطفح الجلدي وانتشار البثور على الجلد.
المصدر: وكالات
إقرأ المزيد

الصحة العالمية: جدري القردة لم يعد حالة طوارئ صحية دولية
أعلن مدير منظمة الصحة العالمية تيدروس أدهانوم غيبريسوس، الجمعة، أن فيروس جدري القردة لم يعد يمثل حالة طوارئ صحية عامة على المستوى الدولي.

بريطانيا تعلن ارتفاع عدد مصابي السلالة الأخطر من فيروس جدري القردة
أعلنت وكالة الخدمات الصحية البريطانية في بيان نشر يوم الاثنين على الموقع الإلكتروني للحكومة، تحديد حالتين أخريين لسلالة جديدة من جدري القردة في المملكة المتحدة.
بفضل قطة.. اكتشاف فيروس "غير مسبوق" قد يشكل تهديدا للبشر
أفادت تقارير باكتشاف فيروس غير مسبوق قد يشكل تهديدا للبشر في ولاية فلوريدا الأمريكية.

جدري القردة يتسلل إلى أكبر دولة سكانيا
أعلنت وزارة الصحة ورعاية الأسرة في الهند، عن عزل أحد المواطنين للاشتباه بإصابته بجدري القردة (mpox).

8 أعراض لجدري القردة ينبغي الحذر منها
أثار تفشي مرض جدري القردة في الكونغو الديمقراطية والدول المجاورة مخاوف العلماء حول العالم، خاصة مع إعلان منظمة الصحة العالمية "حالة طوارئ صحية عامة على الصعيد العالمي".


































































































































































التعليقات